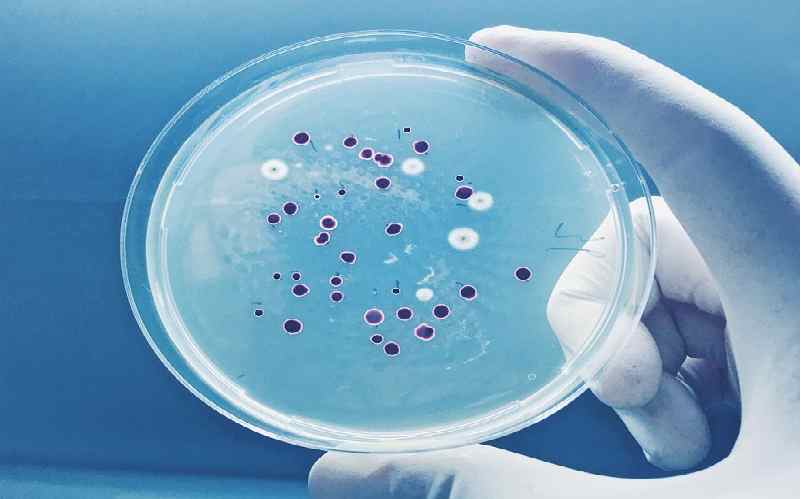

Danh mục sản phẩm
- Sơn và Mực in
- Chất tạo màng
- Hoàn thiện bề mặt kim loại
- Polymer
- Phụ gia thực phẩm
- Hóa dầu
- Thiết bị
- Trang thiết bị y tế
-
Viên gỗ nén
Tìm kiếm sản phẩm
Sơn & Mực in
Ứng dụng của phụ gia kháng khuẩn khuẩn trong sản xuất sơn
Hình minh họa
Sử dụng chất diệt khuẩn cho sơn nước hay dung môi?
Khi sơn được pha chế, có một số khía cạnh cần được lưu ý. Tất nhiên, đầu tiên là hiệu suất của sơn theo công thức. Thứ hai là tính ổn định của sơn, bao gồm duy trì độ nhớt cũng như tối thiểu hoặc không có sự phân tách pha.

Hình minh họa
Nếu chất chống vi khuẩn ít nhất là không thể trộn lẫn, nó sẽ tách ra và có thể tạo thành một lớp mỏng trên bề mặt sơn trong thùng chứa. Trừ khi được khuấy kỹ, sơn phủ lên bề mặt có thể không được chất kháng khuẩn bảo vệ đồng đều. Do đó, khả năng chống nấm mốc và nấm có thể kém.
Các nhà cung cấp chất chống vi khuẩn không phải lúc nào cũng cụ thể về các ứng dụng, vì họ muốn khách hàng sử dụng sản phẩm của họ trong càng nhiều ứng dụng (và do đó số lượng càng lớn) càng tốt. Nhiều TDS cho thấy chất kháng khuẩn có thể trộn lẫn nhẹ trong nước và chỉ hòa tan hoặc trộn lẫn trong một số dung môi nhất định.
Một phương pháp sàng lọc tốt là tạo một hỗn hợp rất đơn giản gồm nhựa và dung môi theo tỷ lệ với lớp phủ và cho vào một chai hoặc lọ nhỏ và lắc mạnh. Kết hợp kháng sinh để xác định xem nó có phải là:
- Tương thích
- Có thể được phân tán
- Lưu trữ phân tán theo thời gian, hoặc
- Không tương thích và không thể phân tán hoặc / và tạo thành hạt.
Chất diệt khuẩn cho sơn ử dụng trong Sơn & Mực in, Nội thất / Ngoại thất?
|
Market |
SB / WB |
Antimicrobial Type |
Chemistry |
||||||
|
In-Can |
Anti-fouling |
Mildewcide / antifungal |
Other |
Organic |
Inorganic |
Blend O |
Blend |
||
|
Paints |
|
|
|
|
X |
X |
|
|
|
|
|
|
X |
X |
X |
|
X |
|
X |
|
|
|
X |
|
|
X |
X |
X |
X |
X |
|
|
|
X |
|
|
X |
X |
X |
X |
X |
|
|
Inks |
|
|
|
|
X |
X |
|
|
|
|
|
X |
|
|
X |
X |
|
X |
|
|
|
Paper Coating |
X |
X |
|||||||

Hình minh họa
Chất kháng khuẩn cho các ứng dụng khác
|
Market
|
SB / WB |
Antimicrobial Type |
Chemistry |
||||||
|
In-Can |
Anti-fouling |
Mildewcide / antifungal |
Other |
Organic |
Inorganic |
Blend O |
Blend |
||
|
Adhesives |
|
|
|
|
X |
X |
|
|
|
|
|
X |
|
|
X |
X |
|
X |
|
|
|
Construction Products |
X |
X |
X |
X |
|||||
|
Textiles |
|
X |
X |
X |
|||||
|
|
X |
X |
X |
X |
X |
||||
|
Paper as raw material |
X |
X |
X |
X |
|||||
Mối quan tâm ứng dụng lớn nhất liên quan đến môi trường pháp lý và khả năng hòa tan. Trước đây, sơn sử dụng một mức chất chống vi khuẩn cụ thể ở một khu vực địa lý trên thế giới, có thể không tuân thủ ở một khu vực địa lý khác do mức độ sử dụng hoặc quy định của địa phương.
Người ta cũng phải biết chất kháng khuẩn sẽ được sử dụng như thế nào. Ví dụ: có các quy định của FDA quy định mức độ sử dụng và hóa chất liên quan đến tiếp xúc trực tiếp hoặc gián tiếp với thực phẩm và các chất kết dính khác, v.v. Trong mỗi trường hợp, vật liệu phải được chấp thuận để sử dụng trong ứng dụng đó, cùng với mức tối đa của sử dụng.
Độ hòa tan quy định độc tính có thể ảnh hưởng đến con người khi tiếp xúc với nước rỉ rác có trong nước và thực vật do độ hòa tan và dòng chảy.
Ảnh hưởng của Môi trường
Môi trường / thời tiết ẩm thấp, ẩm ướt, u ám sẽ khắc nghiệt hơn đối với chất kháng khuẩn.
Ánh nắng mặt trời có thể làm khô bề mặt thường xuyên.
Bản thân tia UV có thể tiêu diệt vi khuẩn (nghĩ rằng tiếp xúc phía Nam so với phía Bắc; nấm mốc và nấm mốc gần như không có).

Hình minh họa
Phạm vi vi sinh vật hiện nay là gì?
Nói chung, bạn sẽ không biết cụ thể những vi sinh vật nào hiện diện, nhưng môi trường mà lớp phủ được áp dụng quyết định điều này. Trong môi trường thể chế, chẳng hạn như bệnh viện, văn phòng bác sĩ, bác sĩ thú y, v.v., sẽ có vi khuẩn và vi rút.
Trong phòng nội thất thường xuyên có độ ẩm> 75% là điều kiện thuận lợi cho nấm mốc, mặc dù vi khuẩn và vi rút cũng sẽ tồn tại.
Bên ngoài khí hậu ẩm ướt và đặc biệt là ở phía bắc của một tòa nhà, nấm mốc và tảo sẽ dễ dàng phát triển. Các vi sinh vật khác không được quan tâm.
Từ khóa:
mdichemical, phụ gia ngành sơn, chất bảo quản, phụ gia chống rêu mốc cho sơn, phụ gia chống thối cho sơn nước, coating additives
THÔNG TIN LIÊN HỆ:
CTY TNHH ĐẦU TƯ VÀ PHÁT TRIỂN THỊ TRƯỜNG HÓA CHẤT (MDI CHEMICAL CO., LTD)
KV Miền Nam: (+84) 28 6256 5573
KV Miền Bắc: (+84) 24 3747 2977
Hotline: (+84) 902 100 571
Website: www.mdi.vn
Email: sales@mdi.vn


